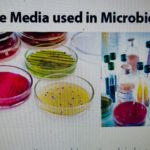
IMG_4636

Posts Slider
Posts Grid
Posts List
Post Single Column
Author
February 9, 2026
1. OBJECTIVE To lay down a procedure for preparation, storage and use of culture media for...
Author
February 8, 2026
OBJECTIVE To lay down a procedure for Environmental Monitoring of Manufacturing Area. 2. SCOPE...
Author
February 8, 2026
OBJECTIVE To lay down a procedure to provide general guideline to be followed in Quality control department...
Author
December 14, 2025
OBJECTIVE To lay down a procedure for maintenance of HPLC column. 2. SCOPE This...
Author
November 16, 2025
OBJECTIVE To lay down a procedure for Environmental Monitoring of Manufacturing Area. 2. SCOPE...